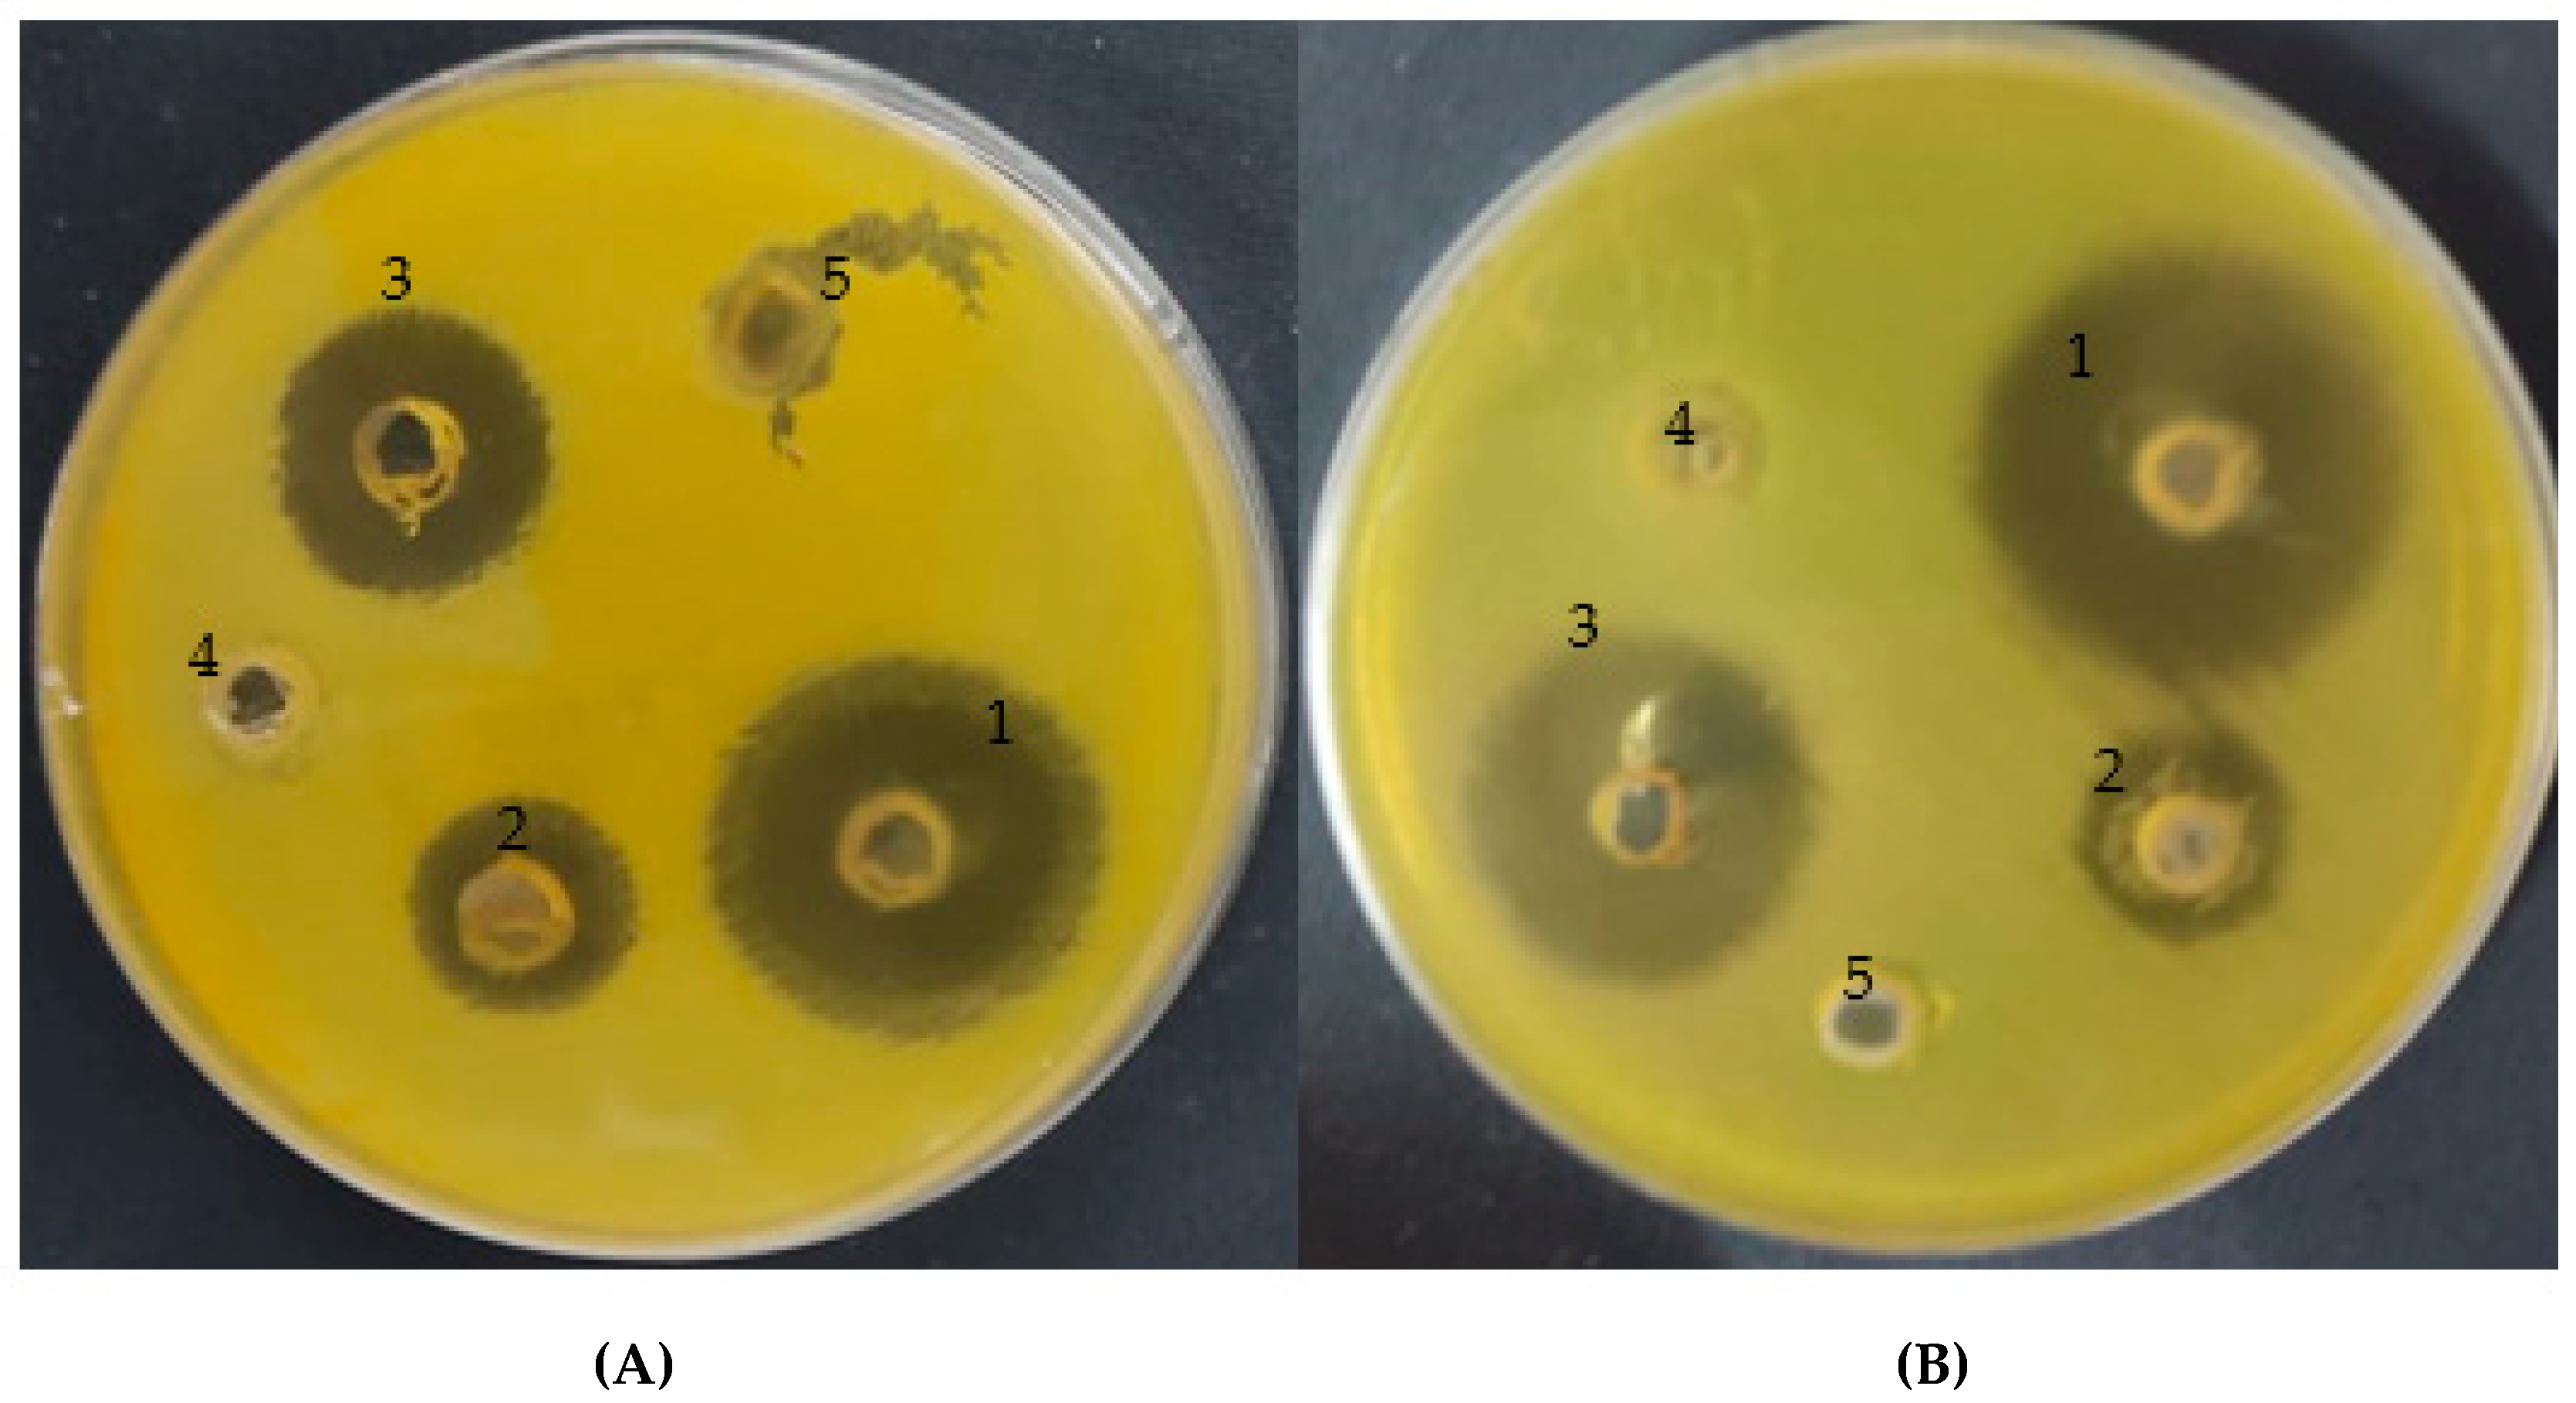

Molecular Docking and Efficacy of Aloe vera Gel Based on Chitosan Nanoparticles against Helicobacter pylori and Its Antioxidant and Anti-Inflammatory Activities
Abstract
:1. Introduction
2. Materials and Methods
2.1. Chemicals Used
2.2. Plant Sample Used and Extraction Process
2.3. Flavonoid and Phenolic Contents Analysis by High-Performance Liquid Chromatography (HPLC)
2.4. Preparation of Coating Solutions of CSNPs with Aloe vera Gel
2.5. Characterization of CSNPs, Aloe vera Gel, and CSNPs Incorporated with Aloe vera Gel
2.5.1. UV–Vis
2.5.2. Transmission Electron Microscopy
2.5.3. Fourier Transform Infrared Spectroscopy
2.6. Antimicrobial Activity of CSNPs, with Aloe vera Gel and CSNPs Incorporated with A. vera Gel
2.7. Minimal Inhibitory Concentration and Minimal Bactericidal Concentration
2.8. Antioxidant Activity
2.9. Preparation of Erythrocyte Suspension and Hypotonicity-Induced Hemolysis
2.10. Molecular Docking
2.11. Statistical Analysis
3. Result and Discussion
3.1. Characterization of A. vera Gel and Phytochemical Analysis
3.2. Characterization of CSNPs and CSNPs Incorporated with A. vera Gel
3.3. Biological Activities of A. vera Gel and A. vera Gel Incorporated to CSNPs
3.3.1. Anti-Helicobacter pylori
3.3.2. Antioxidant Activity
3.3.3. Anti-Hemolytic Activity
3.4. Molecular Docking Study
- Chlorogenic acid interacted via the (4HI0) protein with O 17 and O 23 by donating or accepting their H atoms through O ALA 41 and NZ LYS 195 of receptors.
- The interaction between chitosan and the active site bond of (4HI0) revealed the presence of a hydrogen donor atom between N 15 and N 67 in the ligand and the O ALA 41 and OD1 ASP 40 amino acid residue, in addition to the noncovalent molecular interaction (Cation-Pi) between the N 21 atom in the ligand and 6-ring TYR 48 amino acid receptor.
- The docked pyrocatechol with receptor active sites of (4HI0) indicated the presence of a hydrogen acceptor atom between O 41 of the ligand and the NZ LYS 195 amino acid residue with a distance of 2.85 oA.
4. Conclusions
Author Contributions
Funding
Institutional Review Board Statement
Informed Consent Statement
Data Availability Statement
Acknowledgments
Conflicts of Interest
References
- Bajer, D.; Janczak, K.; Bajer, K. Novel Starch/Chitosan/Aloe vera Composites as Promising Biopackaging Materials. J. Polym. Environ. 2020, 28, 1021–1039. [Google Scholar] [CrossRef] [Green Version]
- Doddanna, S.J.; Patel, S.; Sundarrao, M.A.; Veerabhadrappa, R.S. Antimicrobial activity of plant extracts on Candida albicans: An in vitro study. Indian J. Dent. Res. 2013, 24, 401–405. [Google Scholar] [CrossRef] [PubMed]
- Hęś, M.; Dziedzic, K.; Górecka, D.; Jędrusek-Golińska, A.; Gujska, E. Aloe vera (L.) Webb.: Natural Sources of Antioxidants—A Review. Plant Foods Hum. Nutr. 2019, 74, 255–265. [Google Scholar] [CrossRef] [PubMed] [Green Version]
- Ranjbar, R.; Yousefi, A. Effects of Aloe vera and Chitosan Nanoparticle Thin-Film Membranes on Wound Healing in Full Thickness Infected Wounds with Methicillin Resistant. Staphylococcus aureus. Bull. Emerg. Trauma 2018, 6, 8–15. [Google Scholar] [CrossRef] [PubMed]
- Tayal, E.; Sardana, D.; InduShekar, K.R.; Saraf, B.G.; Sheoran, N. Current perspectives on use of Aloe vera in dentistry. Eur. J. Med. Plants 2014, 4, 1408–1419. [Google Scholar] [CrossRef]
- Shilpa, M.; Bhat, V.; Shetty, A.V.; Reddy, M.S.; Punde, P. Antifungal Activity of Aloe vera Leaf and Gel Extracts Against Candida albicans: An In Vitro Study. World J. Dent. 2020, 11, 36–40. [Google Scholar] [CrossRef]
- Bhandari, A.; Crowe, S.E. Helicobacter pylori in gastric malignancies. Curr. Gastroenterol. Rep. 2012, 14, 489–496. [Google Scholar] [CrossRef] [PubMed]
- Cellini, L.; Di Bartolomeo, S.; Di Campli, E.; Genovese, S.; Locatelli, M.; Di Giulio, M. In vitro activity of Aloe vera inner gel against Helicobacter pylori strains. Lett. Appl. Microbiol. 2014, 59, 43–48. [Google Scholar] [CrossRef]
- Nostro, A.; Cellini, L.; Di Bartolomeo, S.; Di Campli, E.; Grande, R.; Cannatelli, M.A.; Marzio, L.; Alonzo, V. Antibacterial effect of plant extracts against Helicobacter pylori. Phytother. Res. Int. J. Devoted Pharmacol. Toxicol. Eval. Nat. Prod. Deriv. 2005, 19, 198–202. [Google Scholar] [CrossRef]
- Babaee, N.; Zabihi, E.; Mohseni, S.; Moghadamnia, A.A. Evaluation of the therapeutic effects of Aloe vera gel on minor recurrent aphthous stomatitis. Dent. Res. J. 2012, 9, 381–385. [Google Scholar]
- Salem, S.S.; Hammad, E.N.; Mohamed, A.A.; El-Dougdoug, W. A Comprehensive Review of Nanomaterials: Types, Synthesis, Characterization, and Applications. Biointerface Res. Appl. Chem. 2022, 13, 2023. [Google Scholar]
- Hashem, A.H.; Shehabeldine, A.M.; Ali, O.M.; Salem, S.S. Synthesis of Chitosan-Based Gold Nanoparticles: Antimicrobial and Wound-Healing Activities. Polymers 2022, 14, 2293. [Google Scholar] [CrossRef] [PubMed]
- Salem, S.S.; Fouda, A. Green Synthesis of Metallic Nanoparticles and Their Prospective Biotechnological Applications: An Overview. Biol. Trace Elem. Res. 2021, 199, 344–370. [Google Scholar] [CrossRef] [PubMed]
- Shehabeldine, A.M.; Salem, S.S.; Ali, O.M.; Abd-Elsalam, K.A.; Elkady, F.M.; Hashem, A.H. Multifunctional Silver Nanoparticles Based on Chitosan: Antibacterial, Antibiofilm, Antifungal, Antioxidant, and Wound-Healing Activities. J. Fungi 2022, 8, 612. [Google Scholar] [CrossRef] [PubMed]
- Hashem, A.H.; Salem, S.S. Green and ecofriendly biosynthesis of selenium nanoparticles using Urtica dioica (stinging nettle) leaf extract: Antimicrobial and anticancer activity. Biotechnol. J. 2021, 17, 2100432. [Google Scholar] [CrossRef] [PubMed]
- Abdelghany, T.M. Stachybotrys chartarum: A novel biological agent for the extracellular synthesis of silver nanoparticles and their antimicrobial activity. Indones. J. Biotechnol. 2013, 18, 75–82. [Google Scholar]
- Abdelghany, T.M.; Al-Rajhi, A.M.; Al Abboud, M.A.; Alawlaqi, M.M.; Ganash Magdah, A.; Helmy, E.A.; Mabrouk, A.S. Recent Advances in Green Synthesis of Silver Nanoparticles and Their Applications: About Future Directions. A Review. BioNanoScience 2018, 8, 5–16. [Google Scholar] [CrossRef]
- Ganash, M.; Abdel Ghany, T.M.; Omar, A.M. Morphological and biomolecules dynamics of Phytopathogenic Fungi under stress of silver nanoparticles. BioNanoScience 2018, 8, 566–573. [Google Scholar] [CrossRef]
- Salem, S.S. Bio-fabrication of Selenium Nanoparticles Using Baker’s Yeast Extract and Its Antimicrobial Efficacy on Food Borne Pathogens. Appl. Biochem. Biotechnol. 2022, 194, 1898–1910. [Google Scholar] [CrossRef]
- Al-Rajhi, A.M.; Yahya, R.; Bakri, M.M.; Yahya, R.; Abdelghany, T.M. In situ green synthesis of Cu-doped ZnO based polymers nanocomposite with studying antimicrobial, antioxidant and anti-inflammatory activities. Appl. Biol. Chem. 2022, 65, 35. [Google Scholar] [CrossRef]
- Salem, S.S.; Badawy, M.S.E.M.; Al-Askar, A.A.; Arishi, A.A.; Elkady, F.M.; Hashem, A.H. Green Biosynthesis of Selenium Nanoparticles Using Orange Peel Waste: Characterization, Antibacterial and Antibiofilm Activities against Multidrug-R sistant Bacteria. Life 2022, 12, 893. [Google Scholar] [CrossRef] [PubMed]
- Al-Rajhi, A.M.H.; Salem, S.S.; Alharbi, A.A.; Abdelghany, T.M. Ecofriendly synthesis of silver nanoparticles using Kei-apple (Dovyalis caffra) fruit and their efficacy against cancer cells and clinical pathogenic microorganisms. Arab. J. Chem. 2022, 15, 103927. [Google Scholar] [CrossRef]
- Salem, S.S.; Ali, O.M.; Reyad, A.M.; Abd-Elsalam, K.A.; Hashem, A.H. Pseudomonas indica-Mediated Silver Nanoparticles: Antifungal and Antioxidant Biogenic Tool for Suppressing Mucormycosis Fungi. J. Fungi 2022, 8, 126. [Google Scholar] [CrossRef] [PubMed]
- Sharifi-Rad, J.; Quispe, C.; Butnariu, M.; Rotariu, L.S.; Sytar, O.; Sestito, S.; Calina, D. Chitosan nanoparticles as a promising tool in nanomedicine with particular emphasis on oncological treatment. Cancer Cell Int. 2021, 21, 318. [Google Scholar] [CrossRef] [PubMed]
- Alves, N.M.; Mano, J.F. Chitosan derivatives obtained by chemical modifications for biomedical and environmental applications. Int. J. Biol. Macromol. 2008, 43, 401–414. [Google Scholar] [CrossRef] [Green Version]
- Kravanja, G.; Primožič, M.; Knez, Ž.; Leitgeb, M. Chitosan-based (Nano) materials for Novel Biomedical Applications. Molecules 2019, 24, 1960. [Google Scholar] [CrossRef] [PubMed] [Green Version]
- Salama, R.; Osman, H.; Hassan, I. Preparation of biocompatible chitosan nanoparticles loaded with Aloe vera extract for use as a novel drug delivery mechanism to improve the antibacterial characteristics of cellulose-based fabrics. Egypt. J. Chem. 2022, 65, 589–604. [Google Scholar] [CrossRef]
- Amiri, A.; Ramezanian, A.; Mortazavi, S.M.H.; Hosseini, S.M.H.; Yahia, E. Shelf-life extension of pomegranate arils using chitosan nanoparticles loaded with Satureja hortensis essential oil. J. Sci. Food Agric. 2021, 101, 3778–3786. [Google Scholar] [CrossRef]
- Kesharwani, S.; Gupta, D.K.; Gupta, M.K. In-Vitro Evaluation of Drug Release and Antioxidant Activity of Aloe Loaded Chitosan Nanoparticles. J. Drug Deliv. Ther. 2019, 9, 43–52. [Google Scholar] [CrossRef]
- Barrera-Necha, L.L.; Correa-Pacheco, Z.N.; Bautista-Baños, S.; Hernández-López, M.; Jiménez, J.E.M.; Mejía, A.F.M. Synthesis and Characterization of Chitosan Nanoparticles Loaded Botanical Extracts with Antifungal Activity on Colletotrichum gloeosporioides and Alternaria species. Adv. Microbiol. 2018, 8, 286–296. [Google Scholar] [CrossRef]
- Abdelghany, T.M.; Yahya, R.; Bakri, M.M.; Ganash, M.; Amin, B.H.; Qanash, H. Effect of Thevetia peruviana Seeds Extract for Microbial Pathogens and Cancer Control. Int. J. Pharmacol. 2021, 17, 643–655. [Google Scholar] [CrossRef]
- Torlak, E.; Sert, D. Antibacterial effectiveness of chitosan–propolis coated-polypropylene films against foodborne pathogens. International. J. Biol. Macromol. 2013, 60, 52–55. [Google Scholar] [CrossRef] [PubMed]
- Castillo-Juarez, I.; Rivero-Cruz, F.; Celis, H.; Romero, I. Anti-Helicobacter pylori activity of anacardic acids from Amphipterygium adstringens. J. Ethnopharmacol. 2007, 114, 72–77. [Google Scholar] [CrossRef] [PubMed]
- French, G.L. Bactericidal agents in the treatment of MRSA infections–the potential role of daptomycin. J. Antimicrob. Chemother. 2006, 58, 1107. [Google Scholar] [CrossRef] [Green Version]
- López, A.; De Tangil, M.S.; Vega-Orellana, O.; Ramírez, A.S.; Rico, M. Phenolic Constituents, Antioxidant and Preliminary Antimycoplasmic Activities of Leaf Skin and Flowers of Aloe vera (L.) Burm. f. (syn. A. barbadensis Mill.) from the Canary Islands (Spain). Molecules 2013, 18, 4942–4954. [Google Scholar] [CrossRef] [Green Version]
- Guo, X.; Mei, N. Aloe vera: A review of toxicity and adverse clinical effects. J. Environ. Sci. Health. Part C Environ. Carcinog. Ecotoxicol. Rev. 2016, 34, 77–96. [Google Scholar] [CrossRef]
- Hassan, H.S.; EL-Hefny, M.; Ghoneim, I.M.; El-Lahot, M.S.R.A.; Akrami, M.; Al-Huqail, A.A.; Ali, H.M.; Abd-Elkader, D.Y. Assessing the Use of Aloe vera Gel Alone and in Combination with Lemongrass Essential Oil as a Coating Material for Strawberry Fruits: HPLC and EDX Analyses. Coatings 2022, 12, 489. [Google Scholar] [CrossRef]
- Numan, I.N. Identification of Flavonoids and Phenolic Compound in Aloe vera gel by HPLC. Tikrit J. Pure Sci. 2018, 23, 91–94. [Google Scholar]
- Thamilarasan, V.; Sethuraman, V.; Gopinath, K.; Balalakshmi, C.; Govindarajan, M.; Mothana, R.A.; Benelli, G. Single Step Fabrication of Chitosan Nanocrystals Using Penaeus semisulcatus: Potential as New Insecticides, Antimicrobials and Plant Growth Promoters. J. Clust. Sci. 2018, 29, 375–384. [Google Scholar] [CrossRef]
- Vaezifar, S.; Razavi, S.; Golozar, M.A.; Karbasi, S.; Neaz, M.M.; Kamali, M. Effects of Some Parameters on Particle Size Distribution of Chitosan Nanoparticles Prepared by Ionic Gelation Method. J. Clust. Sci. 2013, 24, 891–903. [Google Scholar] [CrossRef]
- Ishkeh, S.R.; Shirzad, H.; Asghari, M.; Alirezalu, A.; Pateiro, M.; Lorenzo, J.M. Effect of Chitosan Nanoemulsion on Enhancing the Phytochemical Contents, Health Promoting Components, and Shelf Life of Raspberry (Rubus sanctus Schreber). Appl. Sci. 2021, 11, 2224. [Google Scholar] [CrossRef]
- Branca, C.; Angelo, G.; Crupi, C.; Khouzami, K.; Rifci, S.; Ruello, G.; Wanderlingh, U. Role of the OH and NH vibrational groups in polysaccharide-nanocomposite interactions: A FTIR-ATR study on chitosan and chitosan/clay flms. Polymer 2016, 99, 614–622. [Google Scholar] [CrossRef]
- Nejatzadeh-Barandozi, F.; Enferadi, S.T. FT-IR study of the polysaccharides isolated from the skin juice, gel juice, and flower of Aloe vera tissues affected by fertilizer treatment. Org. Med. Chem. Lett. 2012, 2, 33. [Google Scholar] [CrossRef] [PubMed] [Green Version]
- Torres-Giner, S.; Wilkanowicz, S.; Melendez-Rodriguez, B.; Lagaron, J.M. Nanoencapsulation of Aloe vera in Synthetic and Naturally Occurring Polymers by Electrohydrodynamic Processing of Interest in Food Technology and Bioactive Packaging. J. Agric. Food Chem. 2017, 65, 4439–4448. [Google Scholar] [CrossRef]
- Prabjone, R.; Thong-Ngam, D.; Wisedopas, N.; Chatsuwan, T.; Patumraj, S. Anti-inflammatory effects of Aloe vera on leukocyte-endothelium interaction in the gastric microcirculation of Helicobacter pylori-infected rats. Clin. Hemorheol. Microcirc. 2006, 35, 359–366. [Google Scholar]
- Gorsi, F.I.; Kausar, T.; Murtaza, M.A. Evaluation of antibacterial and antioxidant activity of Aloe vera (Aloe barbadensis Miller) gel powder using different solvents. Pure Appl. Biol. 2019, 8, 1265–1270. [Google Scholar] [CrossRef]
- Pandey, R.; Mishra, A. Antibacterial activities of crude extract of Aloe barbadensis to clinically isolated bacterial pathogens. Appl. Biochem. Biotechnol. 2010, 160, 1356–1361. [Google Scholar] [CrossRef]
- Abdelghany, T.M.; Ganash, M.; Alawlaqi, M.M.; Al-Rajhi, A.M.H. Antioxidant, antitumor, antimicrobial activities evaluation of Musa paradisiaca L. pseudostem exudate cultivated in Saudi Arabia. BioNanoScience 2019, 9, 172–178. [Google Scholar] [CrossRef]
- Al-Rajhi, A.M.H.; Yahya, R.; Abdelghany, T.M.; Fareid, M.A.; Mohamed, A.M.; Amin, B.H.; Masrahi, A.S. Anticancer, Anticoagulant, Antioxidant and Antimicrobial Activities of Thevetia peruviana Latex with Molecular Docking of Antimicrobial and Anticancer Activities. Molecules 2022, 27, 3165. [Google Scholar] [CrossRef]
- Qanash, H.; Yahya, R.; Bakri, M.M.; Bazaid, A.S.; Qanash, S.; Shater, A.F.; TM, A. Anticancer, antioxidant, antiviral and antimicrobial activities of Kei Apple (Dovyalis caffra) fruit. Sci. Rep. 2022, 12, 5914. [Google Scholar] [CrossRef]

| Flavonoids | Phenolic Acids | ||||
|---|---|---|---|---|---|
| RT * | Compound | Concentration (µg/mL) | RT* | Compound | Concentration (µg/mL) |
| 3.387 | Gallic acid | 466.99 | 8.072 | Rutin | 194.39 |
| 4.465 | Chlorogenic acid | 1637.09 | 10.094 | Ferulic acid | 105.24 |
| 4.745 | Catechin | 1100.43 | 10.478 | Naringenin | 528.78 |
| 5.394 | Methylgallate | 663.41 | 12.266 | Daidzein | 190.72 |
| 5.851 | Caffeic acid | 494.05 | 12.598 | Quercetin | 295.25 |
| 6.518 | Syringic acid | 71.98 | 13.948 | Cinnamic acid | 37.50 |
| 6.909 | Pyrocatechol | 1552.92 | |||
| Strain Test | Inhibition Zone (mm) | ||||
|---|---|---|---|---|---|
| A. vera gel INCORPORATED with CSNPs | A. vera Gel | Control | CSNPs | Acetic Acid | |
| H. pylori (1) | 28 | 16 | 20 | 0 | 0 |
| H. pylori (2) | 30 | 16.5 | 25 | 0 | 0 |
| Compounds | MIC (µg/mL) | MBC µg/mL) | MBC/MIC Index |
|---|---|---|---|
| A. vera gel incorporated with CSNPs | 3.9 | 7.8 | 2.0 |
| A. vera gel | 15.62 | 15.60 | 1.0 |
| Concentration (μg/mL) | A. vera gel Incorporated with CSNPs | A.vera Gel | ||||||
|---|---|---|---|---|---|---|---|---|
| O.D Mean | DPPH Scavenging (%) | SD | SE | O.D Mean | DPPH Scavenging (%) | SD | SE | |
| 1000 | 0.380 | 75.2 | 0.014 | 0.004 | 0.497 | 68.1 | 0.002 | 0.001 |
| 500 | 0.482 | 69.0 | 0.003 | 0.001 | 0.606 | 61.4 | 0.012 | 0.004 |
| 250 | 0.665 | 57.9 | 0.007 | 0.002 | 0.727 | 54.1 | 0.012 | 0.004 |
| 125 | 0.787 | 50.4 | 0.004 | 0.001 | 0.848 | 46.7 | 0.003 | 0.001 |
| 62.5 | 0.907 | 43.1 | 0.014 | 0.004 | 0.969 | 39.3 | 0.006 | 0.002 |
| 31.25 | 1.007 | 37.0 | 0.002 | 0.001 | 1.028 | 35.7 | 0.003 | 0.001 |
| 15.63 | 1.029 | 35.6 | 0.002 | 0.001 | 1.029 | 35.6 | 0.002 | 0.001 |
| 7.81 | 1.105 | 31.0 | 0.003 | 0.001 | 1.117 | 30.3 | 0.003 | 0.001 |
| 3.9 | 1.170 | 27.0 | 0.006 | 0.002 | 1.221 | 23.9 | 0.014 | 0.005 |
| 1.95 | 1.237 | 23.0 | 0.004 | 0.001 | 1.311 | 18.5 | 0.005 | 0.002 |
| 0 | 1.641 | 0.00 | 0.010 | 0.003 | 1.641 | 0.0 | 0.010 | 0.003 |
| IC50 | 81.7 μg/mL | 138.82 μg/mL | ||||||
| Comp | Mol | S | rmsd_ref-n | E_conf | E_place | E_score1 | E_refine | E_score2 |
|---|---|---|---|---|---|---|---|---|
| Chlorogenic acid | ![]() | −6.4876 | 3.5275 | −13.4731 | −59.0633 | −11.5790 | −31.1223 | −6.4876 |
| Chlorogenic acid | ![]() | −6.4831 | 2.4795 | −10.5458 | −66.7119 | −13.6501 | −32.0878 | −6.4831 |
| Chlorogenic acid | ![]() | −6.2798 | 1.6063 | −16.8045 | −77.5656 | −12.1824 | −28.4793 | −6.2798 |
| Chlorogenic acid | ![]() | −6.2138 | 2.1646 | −4.0346 | −85.5775 | −13.3926 | −31.8557 | −6.2138 |
| Chlorogenic acid | ![]() | −6.0663 | 2.0747 | −1.4078 | −61.5997 | −12.1744 | −29.5917 | −6.0663 |
| Chitosan | ![]() | −5.8051 | 3.3384 | 121.2666 | −112.7581 | −13.5777 | −17.1217 | −5.8051 |
| Chitosan | ![]() | −5.3893 | 3.6858 | 112.1133 | −92.1878 | −12.0519 | −30.4200 | −5.3893 |
| Chitosan | ![]() | −5.3659 | 1.6801 | 93.4811 | −83.7728 | −8.3993 | −22.3280 | −5.3659 |
| Chitosan | ![]() | −5.1855 | 4.3113 | 99.2838 | −79.9617 | −8.8196 | −21.6441 | −5.1855 |
| Chitosan | ![]() | −5.1464 | 2.3545 | 97.8875 | −28.5749 | −9.2994 | −26.0396 | −5.1464 |
| Pyrocatechol | ![]() | −5.4074 | 1.3093 | 32.0714 | −36.7848 | −9.6168 | −22.1137 | −5.4074 |
| Pyrocatechol | ![]() | −5.1043 | 3.5432 | 22.2566 | −51.3658 | −9.6291 | −26.8970 | −5.1043 |
| Pyrocatechol | ![]() | −4.9689 | 4.4384 | 25.2747 | −55.7667 | −10.2540 | −25.9606 | −4.9689 |
| Pyrocatechol | ![]() | −4.9671 | 1.2911 | 48.9902 | −62.7305 | −9.7276 | −14.6363 | −4.9671 |
| Pyrocatechol | ![]() | −4.9025 | 2.3984 | 25.1460 | −73.3035 | −9.6229 | −24.9072 | −4.9025 |
| Chlorogenic Acid | Receptor | Interaction | Distance | E (kcal/mol) |
|---|---|---|---|---|
| O 17 | O ALA 41 (A) | H- donor | 2.98 | −0.8 |
| O 23 | NZ LYS 195 (A) | H- acceptor | 2.96 | −3.3 |
| Pyrocatechol | Receptor | Interaction | Distance | E (kcal/mol) |
| O 41 | NZ LYS 195 (A) | H- acceptor | 2.85 | −6.8 |
| Chitosan | Receptor | Interaction | Distance | E (kcal/mol) |
| O 15 | O ALA 41 (A) | H- donor | 2.96 | −2.1 |
| N 67 | OD1 ASP 40 (A) | H- donor | 2.93 | −15.4 |
| N 21 | 6-ring TYR 48 (A) | Cation-Pi | 3.93 | −1.4 |
Publisher’s Note: MDPI stays neutral with regard to jurisdictional claims in published maps and institutional affiliations. |
© 2022 by the authors. Licensee MDPI, Basel, Switzerland. This article is an open access article distributed under the terms and conditions of the Creative Commons Attribution (CC BY) license (https://creativecommons.org/licenses/by/4.0/).
Share and Cite
Yahya, R.; Al-Rajhi, A.M.H.; Alzaid, S.Z.; Al Abboud, M.A.; Almuhayawi, M.S.; Al Jaouni, S.K.; Selim, S.; Ismail, K.S.; Abdelghany, T.M. Molecular Docking and Efficacy of Aloe vera Gel Based on Chitosan Nanoparticles against Helicobacter pylori and Its Antioxidant and Anti-Inflammatory Activities. Polymers 2022, 14, 2994. https://doi.org/10.3390/polym14152994
Yahya R, Al-Rajhi AMH, Alzaid SZ, Al Abboud MA, Almuhayawi MS, Al Jaouni SK, Selim S, Ismail KS, Abdelghany TM. Molecular Docking and Efficacy of Aloe vera Gel Based on Chitosan Nanoparticles against Helicobacter pylori and Its Antioxidant and Anti-Inflammatory Activities. Polymers. 2022; 14(15):2994. https://doi.org/10.3390/polym14152994
Chicago/Turabian StyleYahya, Reham, Aisha M. H. Al-Rajhi, Saleh Zaid Alzaid, Mohamed A. Al Abboud, Mohammed S. Almuhayawi, Soad K. Al Jaouni, Samy Selim, Khatib Sayeed Ismail, and Tarek M. Abdelghany. 2022. "Molecular Docking and Efficacy of Aloe vera Gel Based on Chitosan Nanoparticles against Helicobacter pylori and Its Antioxidant and Anti-Inflammatory Activities" Polymers 14, no. 15: 2994. https://doi.org/10.3390/polym14152994
APA StyleYahya, R., Al-Rajhi, A. M. H., Alzaid, S. Z., Al Abboud, M. A., Almuhayawi, M. S., Al Jaouni, S. K., Selim, S., Ismail, K. S., & Abdelghany, T. M. (2022). Molecular Docking and Efficacy of Aloe vera Gel Based on Chitosan Nanoparticles against Helicobacter pylori and Its Antioxidant and Anti-Inflammatory Activities. Polymers, 14(15), 2994. https://doi.org/10.3390/polym14152994
















